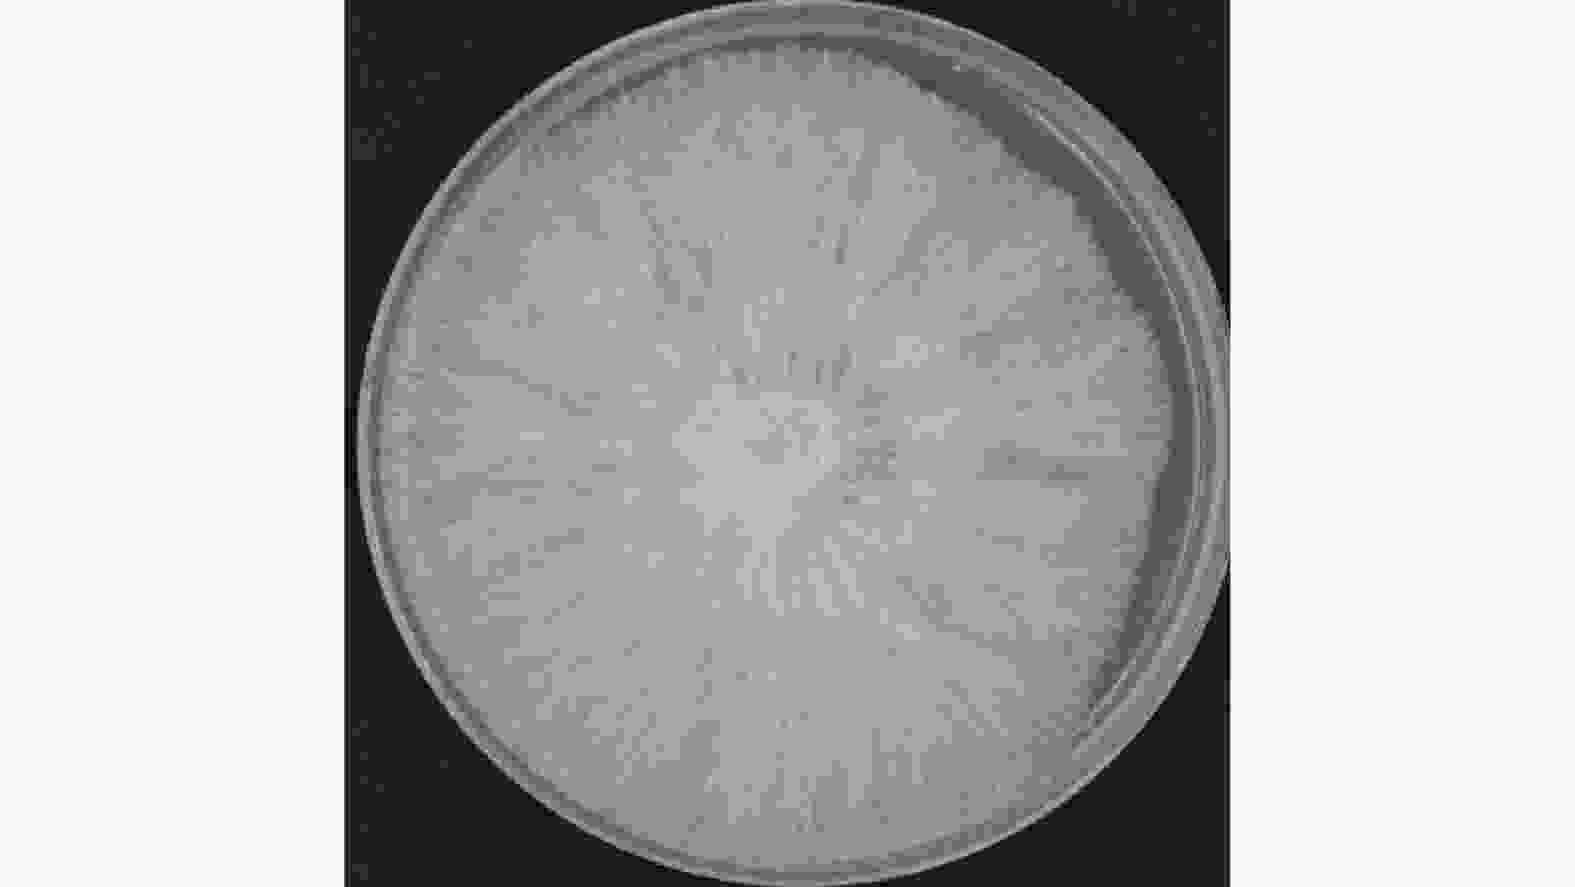

-
红托竹荪(Dictyophora rubrovolvata)是一类珍稀食用菌,属于鬼笔目(Phallales)、鬼笔科(Phallaceae)、竹荪属(Phallus)[1]。最早是藏穆先生在1976年发表于《云南植物研究》中的一个新品种[2-3]。红托竹荪外形优美、口感脆嫩、味道清香,素有“菌中皇后”“真菌之花”和“雪裙仙子”等美称[4],富含丰富的多糖、氨基酸、蛋白质、维生素等营养物质[5-7],具有抗氧化、抗肿瘤、降血糖血脂、免疫调节等功效[8-9],备受市场和消费者喜爱。
目前,在我国广泛种植的4大竹荪(红托竹荪、棘托竹荪Phallus echinovolvata、长裙竹荪Phallus indusiatus、短裙竹荪Phallus duplicatus)中,红托竹荪被公认为品质最优的中温型品种[10]。红托竹荪主要在贵州、云南、四川、福建等地栽培,其中以贵州毕节市、云南昭通市、四川宜宾市、福建三明市和南平市最为有名[11-12]。在海南,红托竹荪的栽培起步较晚,且主要集中在白沙、儋州等地的橡胶(Hevea brasiliensis)林下栽培。橡胶林下栽培红托竹荪,既可凭借林冠郁闭度节约成本,又能通过改良土壤促进胶林健康,从而实现“以林养菌、以菌促林”的复合经营与可持续发展[13]。
红托竹荪对生长环境要求较为严格,尤其菌棒基质和覆土基质对其正常生长至关重要[14]。然而,海南栽培的红托竹荪菌棒多来自贵州等传统产区,这不仅因长距离运输推高成本,也因基质成分不明确带来潜在风险;同时,海南各地胶林的土壤理化性质差异显著,尤其在土壤质地、透气性、有机质含量等方面表现突出,直接影响覆土栽培中菌丝的生长与出菇表现。为系统评估本地化栽培的可行性,本研究选取儋州市光村镇、大成镇和新州镇为代表性试验点,三者土壤性质呈现典型梯度差异:光村镇为肥力较高的重黏土,大成镇与新州镇为肥力较低的砂质黏壤土。该选择覆盖了当地橡胶林下主要土壤类型,可为后续基质优化提供多样化立地条件参照。基于此,本研究通过优化以海南本地树种(橡胶木、相思木(Acacia mangium Willd)、竹子(Phyllostecchys edulis))为碳源、麦麸和豆粕为氮源的菌棒基质,并耦合添加不同比例苔藓泥炭土对儋州三乡镇基土进行复配改良,系统评估其对红托竹荪菌丝生长、子实体发育及产量的影响,以期筛选出适宜海南地区高效低成本栽培模式。
-
试验点位于海南省儋州市临高县波莲镇橡胶林。播种前7 d,胶林行间地块进行翻耕耙平。胶林下搭建镀锌管半拱形遮荫拱棚,棚长30 m,宽6.0 m,高3.0 m。拱棚覆盖塑料棚膜,后期覆盖遮阳网,用于菌棒覆土栽培。
-
供试菌株为“金荪1号”由华融易农农业投资发展(海南)有限公司提供。
-
橡胶木、相思木和竹子取自海南大学儋州校区农科基地,均利用木材破碎机加工成5~8 mm木屑;麦麸和豆粕采购自市场;甘蔗渣、石膏、磷酸二氢钾和硫酸镁等辅料均采购自市场。
-
苔藓泥炭土由华融易农农业投资发展(海南)有限公司提供。试验基土分别为儋州市光村镇、大成镇与新州镇的典型胶林土壤。
-
以橡胶木、相思木及竹子木屑为碳源原料,麦麸和豆粕为氮源原料,根据菌丝生长所需碳氮比30∶1,按照原料质量分数共设计21个配方(表1),其中碳源和氮源原料质量分数为92.7%,辅料均为5%甘蔗渣、1%石膏、1%葡萄糖、0.2%磷酸二氢钾和0.1%硫酸镁。
配方
Formula碳源
Carbon source氮源
Nitrogen source橡胶木/%
Rubber /%相思木/%
Acacia /%竹子/%
Bamboo /%麦麸/%
Wheat Bran/%豆粕/%
Soybean Meal/%A1 72.7 0 0 20 0 A2 62.7 0 0 30 0 A3 67.7 0 0 15 10 A4 67.7 0 0 10 15 A5 72.7 0 0 0 20 A6 62.7 0 0 0 30 B1 0 72.7 0 20 0 B2 0 62.7 0 30 0 B3 0 67.7 0 15 10 B4 0 67.7 0 10 15 B5 0 72.7 0 0 20 B6 0 62.7 0 0 30 C1 0 0 72.7 20 0 C2 0 0 62.7 30 0 C3 0 0 67.7 15 10 C4 0 0 67.7 10 15 C5 0 0 72.7 0 20 C6 0 0 62.7 0 30 D1 10 0 62.7 0 20 D2 30 0 42.7 0 20 D3 50 0 22.7 0 20 Table 1. Formulations of Cultivation Substrates
-
以儋州市光村镇(GC)、大成镇(DC)和新州镇(XZ)胶林土壤为基土,泥炭土分别设置 20%、30%、40%、50%(体积分数)4个梯度添加,以100%基土为对照(CK),共设计15个基质配方。
-
1)栽培菌棒制备:按表1基质配方分别进行拌料处理,提前加水预湿至含水量约60%。按照常规法熟料袋栽法栽培,采用规格120 mm×250 mm×0.05 mm的聚丙烯栽培袋,每袋装湿料300 g。装料后紧实,用塑料套环封口。每个处理设30袋,重复3次。栽培袋在121℃高压灭菌2 h,冷却至常温后,无菌条件下选取形态良好、无污染的红托竹荪原种,用手术刀切取直径约1 cm的菌块,转接至栽培袋袋口中央。接种后,将栽培袋置于25℃恒温发菌室中避光培养。
2)菌棒覆土栽培:在栽培棚内开畦用于菌棒摆放,畦长30.00 m,宽0.40 m,深0.15 m,畦底平整后撒施1层石灰,表面见白即可。菌棒脱袋后平行置于畦中,沿畦边呈“口”字形排列。按照表2中基质配方进行覆土,每处理40个菌棒,重复3次。覆土基质覆盖菌棒后,覆土层高出畦面4 cm。出菇期间,控制棚内温度在25~30℃,大棚遮光率90%,空气湿度保持在 85%~95%。原基形成后,调整棚内温度在18~25℃,大棚遮光率70%,空气湿度保持在 85%~95%。在整个生长和出菇期间,所有处理组均接受相同的水分和施肥管理。
处理组 Treatment 基土 Base soil 泥炭土 Peat GC0(CK) 100% 0 GC1 80% 20% GC2 70% 30% GC3 60% 40% GC4 50% 50% DC0(CK) 100% 0 DC1 80% 20% DC2 70% 30% DC3 60% 40% DC4 50% 50% XZ0(CK) 100% 0 XZ1 80% 20% XZ2 70% 30% XZ3 60% 40% XZ4 50% 50% Table 2. Experimental Design of Different Casing Soil Formulations
-
观测指标包括菌丝生长速度、原基形成时间、出菇时间、集中出菇时间、采收周期、子实体形态指标及产量指标。
1)菌丝生长情况:各配方菌棒随机抽取10袋,分别记录各配方菌丝萌发、生长速度和发满时间,最终取平均值。
2)菌丝长势测定:各配方菌棒随机抽取10袋,分别记录菌丝长势、形态、密度和颜色。菌丝长势分4级,“++++”表示菌丝生长旺盛,“+++”代表菌丝生长良好,“++”菌丝生长状况中等,“+”表示菌丝生长较差。
3)覆土中菌丝长势和出菇形状测定:针对各覆土基质处理的3个重复,分别记录菌丝生长速度、菌丝粗壮度和菌丝密度,“++++”表示菌丝生长旺盛,“+++”代表菌丝生长良好,“++”菌丝生长状况中等,“+”表示菌丝生长较差,“-”表示菌丝不生长。观察记录原基形成时间、出菇时间、集中出菇时间和采收周期。
4)红托竹荪形态和产量测定:在各处理组中的3次重复随机各选取30个单菇,共计90个单菇,分别记录菌蕾直径、菌柄长度、菌柄粗度、菌盖长度和菌盖粗度,计算单菇质量平均值。以各处理组中120个菌棒为标准,计算单个菌棒产量、菌蕾数量和总产量。
-
试验数据采用DSPS 和Excel软件进行数据处理和分析,用 Duncan 新复极差法进行差异显著性检验。
-
共设置橡胶木屑、相思木屑、竹屑3种碳源,麦麸和豆粕两种氮源。结合表3 各菌棒基质配方,从红托竹荪菌丝生长情况来看,橡胶木屑作为碳源的基质配方表现最佳,菌丝萌发时间较短,均为4 d,且菌丝长势和颜色均优于其他处理。其中,A5(图3-E)配方处理菌丝生长速度最快(12.62 mm·d−1),满袋时间最短(16.33 d),菌丝浓密粗壮,色泽洁白。以相思木屑作为碳源的基质配方次之,满袋时间23.00~25.33 d,菌丝较为稀疏,部分呈灰白色;而以竹屑为碳源的配方表现最差,菌丝萌发时间较长,菌丝生长速度较慢,满袋时间延长至23.00~27.67 d,菌丝多呈微黄色;混合碳源的基质配方各项指标居中,菌丝长势较好,但颜色呈微黄。综合比较A、B、C、D 4个处理组中各配方的表现,菌丝生长速度最快、满袋时间最短的处理均为添加20%(质量分数)豆粕的配方,表明在麦麸与豆粕两种氮源中,豆粕更适宜红托竹荪菌丝生长。
配方
Formula萌发时间/d
Germination
time /d满袋时间/d
Full colonization
time/d菌丝生长速度/ mm·d−1
Mycelial growth rate /
(mm·d−1)菌丝长势
Mycelial
growth菌丝形态
Mycelial
morphology菌丝颜色
Mycelial colorA1 4 18±0 d 10.52±3.70 b ++++ 绒状Tomentose 洁白
WhiteA2 4 19.33±0.58 c 9.19±1.50 c +++ 绒状Tomentose 洁白
WhiteA3 4 20.67±0.58 b 9.03±0.88 c +++ 绒状Tomentose 洁白
WhiteA4 4 22.67±0.58 a 7.91±1.08 d ++++ 绒状Tomentose 洁白
WhiteA5 4 16.33±0.58 e 12.62±3.23 a ++++ 绒状Tomentose 洁白
WhiteA6 4 21.00 b 8.92±1.13 c ++++ 绒状Tomentose 洁白
WhiteB1 4 23.00 c 7.70±4.00 a ++ 绒状Tomentose 灰白 B2 4 24.00 b 6.95±0.50 b +++ 绒状Tomentose 微黄 B3 5 24.68±0.58 ab 5.93±0.58 c +++ 绒状Tomentose 微黄 B4 5 25.33±0.58 a 5.10±2.65 d +++ 绒状Tomentose 灰白 B5 4 23.00 c 7.80±1.00 a +++ 绒状Tomentose 微黄 B6 5 24.67±0.58 ab 6.73±2.00 b +++ 绒状Tomentose 灰白 C1 4 24.00 c 7.68±0.76 b +++ 绒状Tomentose 微黄 C2 5 24.33±0.58 c 7.10±1.00 c +++ 绒状Tomentose 灰白 C3 4 24.68±0.58 c 6.12±1.89 d +++ 绒状Tomentose 微黄 C4 6 26.67±0.58 a 5.03±1.53 e +++ 绒状Tomentose 微黄 C5 4 23.00 d 8.00±1.00 a +++ 绒状Tomentose 微黄 C6 4 25.67±0.58 b 6.90±1.73 c +++ 绒状Tomentose 微黄 D1 4 23.33±0.58 b 8.01±0.42 a +++ 绒状Tomentose 微黄 D2 4 23.00 a 8.33±0.21 a +++ 绒状Tomentose 微黄 D3 4 23.00 ab 8.07±0.32 a +++ 绒状Tomentose 微黄 注:数据为平均值±标准差;同列不同小写字母表示差异显著(P<0.05)。 Note: Data are presented as mean ± standard deviation. Different lowercase letters indicate significant differences (P< 0.05). Table 3. Mycelial growth of Dictyophora rubrovolvata under different formulas
-
由表4结果可知,在基土中添加苔藓泥炭土可以显著提升红托竹荪的菌丝生长速度、菌丝长势及出菇表现。其中,光村镇基土中20%泥炭土添加量处理组效果最佳,红托竹荪出菇时间和采收周期最短;大成镇基土中30%泥炭土添加量处理组效果最佳,出菇时间显著提前,集中出菇更为整齐,采收周期缩短;新州镇基土中40%泥炭土添加量处理组在原基形成时间、出菇时间与采收周期方面均表现突出。大成镇和新州镇基土对照组中均未能正常出菇,表明泥炭土的添加对红托竹荪生长至关重要。
处理组
Treatment菌丝生长速度
Mycelial growth菌丝粗壮度
Mycelial
thickness菌丝密度
Mycelial
density原基形成时间/d
Primordium
formation time/d出菇时间/d
Fruiting
time/d集中出菇时间/d
Peak fruiting
period
/d采收周期/d
Harvesting
duration /dGC0(CK) + ++ ++ 37.17±0.29 a 129.50±0.50 a 135.67±0.58 a 27.33±0.58 a GC1 +++ +++ +++ 29.33±0.29 b 115.17±0.29 d 125.33±0.29 c 19.00 c GC2 +++ +++ +++ 28.17±0.29 c 120.50±0.50 c 125.67±0.58 c 19.50±0.50 c GC3 +++ +++ +++ 27.00 d 120.67±0.58 c 124.00 d 20.33±0.29 b GC4 +++ +++ +++ 28.33±0.29 c 121.50±0.50 b 127.00 b 20.67±0.58 b DC0(CK) - +++ + 46.33±0.58 a 0 0 0 DC1 ++ ++++ +++ 37.17±0.29 b 115.33±0.58 c 120.33±0.29 b 20.33±0.58 a DC2 ++ ++++ +++ 36.33±0.58 c 111.50±0.5 d 119.33±0.58 c 17.50±0.50 b DC3 ++ ++++ +++ 34.33±0.29 d 116.17±0.29 b 120.83±0.29 b 17.67±0.58 b DC4 ++ ++++ +++ 35.00 d 122.00 a 128.67±0.29 a 21.17±0.29 a XZ0(CK) - - - 0 0 0 0 XZ1 ++ ++++ +++ 32.00 a 116.33±0.58 125.33±0.58 26.33±0.58 XZ2 ++ ++++ +++ 31.17±0.29 b 114.83±0.76 121.17±0.29 23.50±0.50 XZ3 ++ ++++ +++ 30.00 c 110.83±0.76 122.67±1.15 23.33±0.58 XZ4 ++ ++++ +++ 30.96±0.81 b 117.50±0.50 126.00±0 25.50±0.50 注:同列不同小写字母表示差异显著(P<0.05)。 Note: Different lowercase letters indicate significant differences (P< 0.05). Table 4. Growth and fruiting of Dictyophora rubrovolvata under different casing soil formulas
-
从表5结果可知,各处理组中红托竹荪菌蕾直径均无显著差异。光村镇各泥炭土添加处理组的红托竹荪菌柄长度、菌柄粗度、菌盖长度、菌盖粗度等指标相比基土对照组均有显著差异。因大成镇和新州镇基土对照组未见出菇,其他不同比例泥炭土添加处理组无法与对照组进行各形态指标对比。大成镇不同比例泥炭土添加处理组之间在菌蕾直径、菌盖长度和菌盖粗度上没有显著差异,在菌柄长度和菌柄粗度上有显著差异。新州镇不同比例泥炭土添加处理组在各形态指标上均没有显著差异。
处理组
Treatment菌蕾直径/mm
Primordium diameter/mm菌柄长度/mm
Stipe length /mm菌柄粗度/mm
Stipe diameter /mm菌盖长度/mm
Cap length /mm菌盖粗度/mm
Cap diameter /mmGC0(CK) 51.4±7.25 a 141.46±19.91 a 31.22±3.52 a 45±4.39 a 40.42±3.94 a GC1 51.32±5.86 a 128.11±16.85 b 28.15±3.88 b 40.38±5.57 b 35.95±5.44 b GC2 48.72±4.26 a 129.73±13.32 b 29.15±3.81 ab 38.26±4.98 b 35.19±3.63 b GC3 48.51±3.25 a 130.72±14.85 ab 28.97±3.25 ab 38.71±5.02 b 34.90±4.80 b GC4 48.26±4.16 a 131.77±11.87 ab 30.66±3.49 ab 40.17±4.61 b 36.55±3.67 b DC0(CK) 0 0 0 0 0 DC1 48.57±3.86 a 123.75±9.10 b 27.21±2.70 b 40.61±4.72 a 34.28±3.5 a DC2 46.79±4.22 a 141.39±13.26 a 28.41±1.90 ab 42.19±5.57 a 34.93±3.42 a DC3 47.48±4.34 a 129.01±19.00 b 28.88±2.77 ab 38.92±4.04 a 35.01±3.78 a DC4 46.66±4.5 a 134.08±19.13 ab 29.83±4.19 a 41.35±5.00 a 35.87±6.63 a XZ0(CK) 0 0 0 0 0 XZ1 51.25±6.44 a 136.73±16.39 a 31.90±3.60 a 44.12±7.71 a 40.33±5.33 a XZ2 49.57±4.09 a 130.82±17.10 a 30.51±3.53 a 43.27±3.95 a 38.30±4.09 a XZ3 50.80±5.62 a 131.25±14.67 a 29.91±3.12 a 42.93±6.56 a 38.24±2.47 a XZ4 48.32±4.77 a 133.40±23.70 a 30.71±4.44 a 43.97±6.15 a 38.92±4.86 a 注:每个处理组选90个,其中每个重复随机选取30个单菇进行指标测定,数据为平均值±标准差。同列不同小写字母表示差异显著(P<0.05)。 Note: Each treatment group consisted of 90 mushrooms, with 30 randomly chosen from each of the three replicates for measurement. Data are presented as mean ± standard deviation. Different lowercase letters indicate significant differences (P< 0.05). Table 5. Morphology of Dictyophora rubrovolvata under different casing soil formulas
-
由表6结果可知,光村镇不同比例泥炭土(图4)添加量处理组在单棒产量、单菇质量、菌蕾数量和总产量相对对照组均有显著提升。其中,以20%比例泥炭土添加量的单个菌棒产量、单菇质量和总产量最高。因大成镇和新州镇基土对照组未见出菇,其他不同比例泥炭土添加处理组无法与对照组进行产量指标对比。大成镇(图5)30%泥炭土添加量处理组表现最佳,单个菌棒产量、菌蕾数量、总产量均最高。新州镇(图6)30%泥炭土添加量处理组单棒产量和总产量均最高。
处理组
Treatment单个菌棒产量/g
Yield per bag /g单菇质量/g
Fresh weight per sporocarp /g菌蕾数量/个
Number of primordia总产量/g
Total yield /gGC0(CK) 14.38 10.38±0.87 b 240 1725.80 GC1 93.76 12.99±0.76 a 978 11251.44 GC2 64.23 12.22±0.70 ab 1074 7707.52 GC3 83.70 11.48±1.03 ab 1086 10044.21 GC4 63.45 12.63±1.40 a 1137 7615.11 DC0(CK) 0 0 27 0 DC1 90.54 10.12±0.70 b 1101 10864.56 DC2 103.58 11.12±0.24 ab 1281 12429.91 DC3 99.96 12.65±1.07 a 1158 11995.35 DC4 62.11 12.64±1.81 a 735 7453.85 XZ0(CK) 0 0 3 0 XZ1 68.58 13.57±0.70 b 576 8229.09 XZ2 92.66 15.48±0.78 ab 726 11118.90 XZ3 80.70 16.35±1.75 a 768 9684.13 XZ4 57.79 16.25±0.44 a 643 6934.27 注:单个菌棒产量=总产量÷120个菌棒;单菇质量:90个单菇的平均质量。数据为平均值±标准差。同列不同小写字母表示差异显著(P<0.05)。 Note: Yield per bag = Total yield ÷ 120(number of bags); Fresh weight per sporocarp = average data from 90 sporocarps per treatment group. Data are presented as mean ± standard deviation. Different lowercase letters indicate significant differences (P<0.05). Table 6. Effects of Different Casing Soils on the Yield Indicators of Dictyophora rubrovolvata
-
优质的菌棒基质既可以稳定食用菌栽培微环境、锁定充足的水分,又可以为菌丝提供充足的营养,对菌丝生长和子实体的发育至关重要[15]。其中,碳、氮源是食用菌生长必需的两大类营养物质,且食用菌种类不同,对碳氮需求也不同。此外,在菌丝体生长和子实体分化不同阶段,碳、氮原料的用量与比例也需相应调整[16]。碳源是食用菌中糖类和氨基酸合成的基本原料,可以为菌体呼吸代谢提供能量来源。对于红托竹荪,栽培阶段所需的碳源主要依赖于木质纤维素,主要以阔叶林树木材为主,部分地区次采用竹类材料。研究表明木块混料栽培相对于单一营养源的木块栽培具有菌丝生长速度快、栽培周期短等优点,且原材料的广泛性有助于缓解竹荪栽培木材用量大给环境带来的压力[17]。本研究中采用橡胶木、相思木和竹子分别作为单一碳源原料,并设计橡胶木和竹子的混料配方,结果发现混料栽培配方相对其他单一碳源配方菌丝生长速度快,但是菌丝长势和颜色不佳。欧胜平利用楠竹作为碳源基质栽培的红托竹荪菌丝生长速度和出菇产量均优于木屑[17]。白会超[18]发现60%竹屑和40%木屑作为主料栽培棘托竹荪菌丝生长速度最快,菇蕾数和产量也优于100%竹屑配方。报道发现红托竹荪对不同栽培基质中木质纤维的降解规律不同,菌丝生长阶段以木质素为主,子实体生长阶段以纤维素为主[17]。本研究中采用海南本地毛竹和橡胶木,不同基质木质纤维素含量不同,这或许成为影响菌丝生长的关键。开展红托竹荪不同栽培阶段木质纤维素降解酶的研究,将有助于对栽培基质中木质纤维素降解机理的了解,进一步对红托竹荪的营养特性进行解析,为红托竹荪标准化栽培提供依据。
氮源是食用菌合成蛋白质、核酸和细胞壁等重要物质的基础原料。目前研究发现复合氮源优于单组分氮源,有机氮效果优于无机氮[19]。本研究分别采用麦麸、豆粕作单一氮源和二者的复合氮源,发现复合氮源的栽培配方中红托竹荪菌丝生长速度最快。刘福阳等研究发现以麦麸和豆粕为氮源的栽培基质比尿素中竹荪菌丝生长速度更快,菌丝密度更浓,现蕾时间更早,而以麦麸为氮源时竹荪产量最高[15]。对于长裙竹荪和棘托竹荪,以黄豆粉作为氮源的栽培基质比蛋白胨和尿素菌丝长势好[20]。在香菇栽培中,以麦麸和豆粕组合的栽培配方产量最高[21]。但是,本研究中栽培基质综合表现最佳的是以豆粕为单一氮源的A5配方,由此可见不同食用菌对氮源的需求不一,红托竹荪对豆粕的营养利用效果较好。因此在实际生产中,要根据食用菌的生长特性差异,对碳、氮元素的具体需求设计合理栽培基质[22]。此外,伴随食用菌从菌丝体生长到子实体发育过程,菌株对碳、氮元素的需求也会发生变化。栽培过程中,碳、氮源添加比例根据栽培原料和食用菌种类变化而变化,碳氮比值太大或者太小均会影响菌丝体的生长[23]。一般菌株菌丝体生长阶段最佳碳氮比在20∶1,子实体发育阶段最佳碳氮比在30~40∶1[19]。因不同栽培原料的碳氮物质含量不同,且红托竹荪不同生长阶段所需碳氮比也不同,因此本研究所设计处理组依据碳氮比20∶1—70∶1之间设计了不同碳氮源、不同碳氮比的栽培基质配方,菌丝整体长势较好,其中以72.7%橡胶木屑和20%豆粕的基质菌丝生长速度、满袋时间、菌丝颜色等均最佳,碳氮比为26∶1。但是,不能确定这就是红托竹荪栽培基质最优的碳氮比,后续仍需开展不同碳氮比配方研究,进一步试验和验证其对红托竹荪产量和质量的影响效果。
覆土栽培是食用菌栽培种常用的一种栽培技术。土壤因子对食用菌的生长发育、出菇产量和品质都有影响[24]。覆土可以作为天然的物理屏障,同时为食用菌的生长提供营养补充。当菌丝体生长到一定阶段后,覆土成为刺激子实体形成的必要环节,尤其是双孢菇、鸡腿菇等具有不覆土不出菇的特性[25]。本研究结合红托竹荪的野外生长特性,进行畦式覆土栽培方式,整体菌丝生长和子实体发育正常。该栽培方式在袋栽平菇生产中具有管理方便,易于补水、补养,且出菇潮次多、出菇商品性好,生物转化率高等优点[26]。但是,大成镇和新州镇100%基土覆土基质没有出菇,推测可能与土壤性质有关。土壤中的含砂量直接关系到其透气性能和持水率,对食用菌的栽培产量和质量发挥直接作用[27]。另外,土壤中有机质含量对于子实体的发育和品质也很重要。生产中覆土一般直接用原地土,土壤肥力有时可能达不到食用菌所需要的有机质的含量,通过外源添加一定比例的有机质含量高的物质有利于出菇产量与质量的稳定性[28]。赵呈明研究发现在菜田土中1∶1比例添加泥炭土双孢菇可提前出菇,产量也相应提高[29]。大球盖菇在富含有机质的且质地疏松的过筛园土与泥炭土的覆土材料中产量也是最高的[30]。蚯蚓粪[31]、秸秆发酵料[32]等富含有机质的材料均被应用到食用菌栽培中,旨在降低生产成本的同时,提高食用菌产量和品质。但是,目前关于红托竹荪覆土栽培材料的研究相对较少。本研究在基土中进行不同比例泥炭土添加,发现外源有机质的增加对于菌丝的长势、产量等均有良好效果。在食用菌生产栽培阶段,肥料的施用也至关重要,这也将是后续试验的重点。为更好的降低生产成本,提高红托竹荪产量,只有建立标准的栽培技术体系的研发,才能为其在海南的大面积推广奠定良好基础。
-
以橡胶木屑为碳源菌丝生长较好,豆粕为氮源较麦麸好,最优配方为A5,具体为72.7%橡胶木屑、20%豆粕、5%甘蔗渣、1%石膏、1%葡萄糖、0.2%磷酸二氢钾和0.1%硫酸镁,菌丝生长速度达12.62 mm·d−1,满袋时间为16.33 d,菌丝浓密粗壮且洁白。
海南儋州地区土壤主要为黏壤土,使用本土种植红托竹荪产量偏低甚至绝收,在覆盖土中添加20%~30%的苔藓泥炭土可显著提升产量和品质,提高种植效益。
Optimization of mushroom-stick substrate and casing soil for Dictyophora rubrovolvata in Danzhou area, Hainan Province
DOI: 10.15886/j.cnki.rdswxb.20250179
- Received Date: 2025-11-26
- Accepted Date: 2026-02-26
- Rev Recd Date: 2026-01-22
-
Key words:
- Dictyophora rubrovolvata /
- tropical region /
- mushroom-stick substrate /
- casing soil
Abstract: To address the issues of high cost and low yield in the cultivation of Dictyophora rubrovolvata in Hainan, this study conducted a gradient experiment to optimize the mushroom-stick substrate and casing soil composition. Key parameters, including mycelial growth rate, bag-filling time, primordia formation time, fruiting time, fruiting body morphological characteristics, and yield, were measured to evaluate the effects of different carbon sources, nitrogen sources, and organic matter on the growth of D. rubrovolvata. The results indicated that the A5 substrates formula, containing rubberwood as the carbon source and soybean as the nitrogen source, exhibited the best performance. It achieved a mycelial growth rate of 12.62 mm·d-1, a bag-filling time of 16.33 d, and produced dense, robust, and pure white mycelia. The addition of sphagnum peat to the casing soil at varying ratios enhanced mycelial growth, shortened the time to primordia formation and fruiting, and increased yield. Specifically, the highest yield per stick (93.76 g) were achieved with the application of 20% peat to the base soil from Guangcun Town. The application of 30% peat to the base soil from Dacheng Town resulted in the highest yield per stick (103.58 g) and. Similarly, the addition of 30% peat to the Xinzhou Town base soil yielded at 92.66 g per stick This study provides a theoretical basis and technical support for the efficient and low-cost cultivation of D. rubrovolvata in tropical regions.
| Citation: | Sun Shichen, Yu xudong, Wang Tongxin, Yu Jiakun, Zhang Bingxiang, Luo Can. Optimization of mushroom-stick substrate and casing soil for Dictyophora rubrovolvata in Danzhou area, Hainan Province[J]. Journal of Tropical Biology. doi: 10.15886/j.cnki.rdswxb.20250179 |

DownLoad:
DownLoad:





